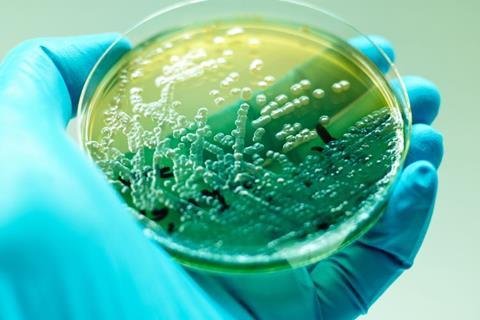
Image

Research suggests the rapid detection method “will enable the timely implementation of microbiological monitoring strategies for large batches of medications”.
Findings from an experimental study report the development of a rapid method for the detection of pseudomonas aeruginosa bacteria in medications.
The corresponding research paper stated the key benefits of the method include its high selectivity and specificity, cost-effectiveness as well as simplicity for application. For example, the author shared that the procedure can be used in microbiological laboratories of various levels.
In the paper, the author acknowledged that topical medicinal products require the absence of bacterial species such as P. aeruginosa.
However, the methods commonly used for identifying microorganisms in medications are lengthy and time-consuming, the paper highlighted. As such, development of rapid methods for detecting unacceptable microorganisms in medications is a key industry priority, Puscas noted.
In the paper, it was reported that the studies indicated a clear increase in the sensitivity and speed of detection of P. aeruginosa bacteria in pure culture, mixed culture, or other research materials.
The study used medications labelled as “sterile, oral and topical preparations, components of formulations for micro-pellicle media, re-agents, and chemical compounds for achieving selectivity, factors promoting multiplication, and inhibition factors.”
Optimising microbial detection
The paper proposed a new culture medium that includes all optimal ingredients for the detection of P. aeruginosa bacteria:
- Sodium malonate as a specific substrate
- Water-soluble bromothymol blue as an indicator
- Sodium hydrogen phosphate
- Potassium dihydrogen phosphate.
the proposed medium is much more sensitive compared to blood agar and peptone agar media, allowing for the detection of P. aeruginosa bacteria within six hours"
Individual P. aeruginosa cells were detected after nine to 12 hours of incubation. Results for concentrations of 104-105 colony forming units (CFUs) were obtained within five to six hours, according to Puscas, who authored the paper. Specifically, the proposed medium is much more sensitive compared to blood agar and peptone agar media, allowing for the detection of P. aeruginosa bacteria within six hours.
Study method and results
For detecting P. aeruginosa bacteria in the bottle with the medium, the author stated that “2.0ml of sterile distilled water and the strain of P. aeruginosa in a concentration of 101.... 109” were applied. The medium dissolved within two to three minutes, then was incubated in a thermostat at 37°C for up to nine hours.
“In the presence of P. aeruginosa bacteria in the examined material, the colour of the mixture in the bottle changes from green to blue. In the control bottle, the colour stayed green,” Puscas explained.
Conclusion
Overall, the method facilitates the “timely monitoring of pharmaceutical preparations and resources to limit contamination throughout the pharmaceutical manufacturing process,” the author asserted.
The method is valuable because an increase in the number of pharmaceutical recalls in recent years has highlighted the importance of the microbiological quality of medicines, the author shared. Due to its use in the rapid detection of P. aeruginosa, “the accuracy of the results will enable the timely implementation of microbiological monitoring strategies for large batches of medications,” Puscas concluded.
The paper was published in The Scientific Journal of the Moldavian of Biosafety & Biosecurity Association.


